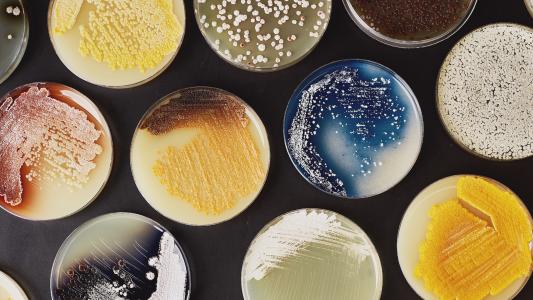

Why happiness is not the best indicator of well-being
Achieving values and pursuing growth is the real secret to a fulfilled life.
How Arc Institute is bringing science into the century of biology
Researchers at Arc Institute all work toward the same goal: make concrete progress in understanding and treating complex diseases.
Plant sensors could act as an early warning system for farmers
Using sensors made from carbon nanotubes, researchers discovered signals that help plants respond to stresses like heat, light, or attack.
Anne Trafton | MIT News Office